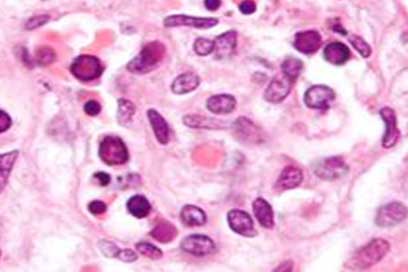
Parvo virus

The name Parvo is very misleading,
as the disease cannot spread from cats to dogs, although cats can contract a similar disease. Furthermore, the gut is affected and no typical flu symptoms found.The disease is more common in dry, windy conditions and mainly affects young dogs, although any dog that has not been exposed to the virus, can get sick. Even with the best treatment there are a percentage of animals to recover and therefore vaccination is extremely important in the prevention of the disease.Parvo virus cannot affect humans.
The virus needs certain enzymes found only in fast-growing cells.The cells on the inside of the gut are growing extremely fast, so much so that the inner layer of the intestines is replaced every two to three days. As the virus in these cells divide, the cells are destroyed and large areas of damaged mucosa are formed, through which body fluids and even blood oozes and bacteria normally is harmless, enter the body.
SYMPTOMS
- Often high fever
- Apathy
- Loss of appetite
- Persistent vomiting, foaming at the mouth
- Bad smelling, later bloody diarrhoea
- Gum white or bluish
- Abdominal pain
- Rapid dehydration
The symptoms usually appear suddenly and dogs can die within a few hours. Animals that have antibodies to the virus will acquire the disease in a milder degree. Although it seldom happens, the virus can affect the heart muscle with fatal consequences.
DIAGNOSIS
In most cases the history and symptoms are very suspicious for a diagnosis. Nowadays there are easy tests available that pick up the virus in manure. Although these tests sometimes give false positive results, it is a very good tool to decide whether the animal had parvo.
TREATMENT
There are currently no cheap injectable drugs that kill the virus in the body, so there is no specific treatment as longs as the virus is in the body. The treatment therefore involves the suppression of bacteria in the gut, preventing vomiting and restore the moisture content of the body.
- Antibiotics
- Anti-vomiting Drugs
- Intravenous drip
- Rather Flora or other probiotic intestinal flora (beneficial bacteria) to supplement
- Activated charcoal tablets to neutralize toxins
- Oral electrolytes if vomiting ceased
- Feeding small amounts of food that contains no fat eg. rice and chicken
- In severe cases, blood transfusion or the administration of plasma
PREVENTION
It is extremely important that females that bred receive vaccinations on a regular basis. Puppies from six weeks of age must be vaccinated against the disease and every four weeks thereafter until they are fourteen weeks old.If you had a dog on the property that died from this serious illness, you should try and disinfect all solid surfaces with chlorine or a strong disinfectant such as F10.Under no circumstances should a puppy that has not had at least two vaccinations be brought on the site.The virus is quite persistent and can survive very long in the environment.With proper vaccination the disease can be stopped to a large extent.
This serious disease is one of the smallest disease organisms - a virus called Dogs Parvovirus (parvo meaning small) The virus is so small that about 300 thousand fit side by side in a millimetre. Despite the size of the virus, it is one of the toughest viruses - under favourable circumstances it can take up to two years to survive in the environment.The virus can even be worn on a person's shoe soles and that is how the disease within a few months in 1978 spread around the world. Huge numbers of the virus can live in the vomit and faeces of sick animals.One gram of manure contains enough viruses to spread to more than 10 million dogs!